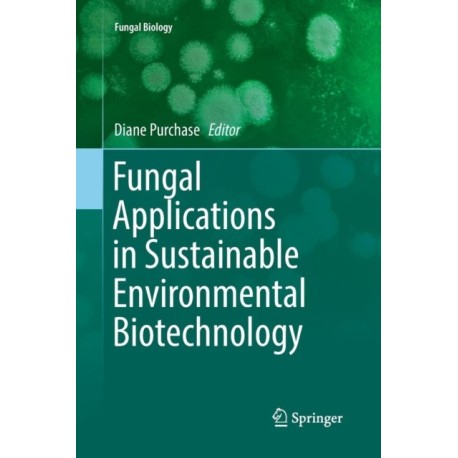

Kurv
Vare
varer
(tom)
Ingen varer
Fastlægges senere
Forsendelse
0,- kr
I alt
Fungal Applications in Sustainable Environmental Biotechnology
(Bog, Paperback / softback, Engelsk)
Læsernes anmeldelser (0)
Alle detaljer
| Forlag | Springer International Publishing AG |
| Type | Bog |
| Format | Paperback / softback |
| Sprog | Engelsk |
| Udgave | Softcover reprint of the original 1st ed. 2016 |
| Udgivelsesdato | 14-06-2018 |
| Første udgivelsesår | 2018 |
| Serie | Fungal Biology |
| Illustrationer | 24 Illustrations, color; 20 Illustrations, black and white |
| Fagredaktør | Diane Purchase |
| Originalsprog | Switzerland |
| Sideantal | 405 |
| Indbinding | Paperback / softback |
| Forlag | Springer International Publishing AG |
| Sideoplysninger | 405 pages, 24 Illustrations, color; 20 Illustrations, black and white |
| Mål | 235 x 155 |
| ISBN-13 / EAN-13 | 9783319826806 |


